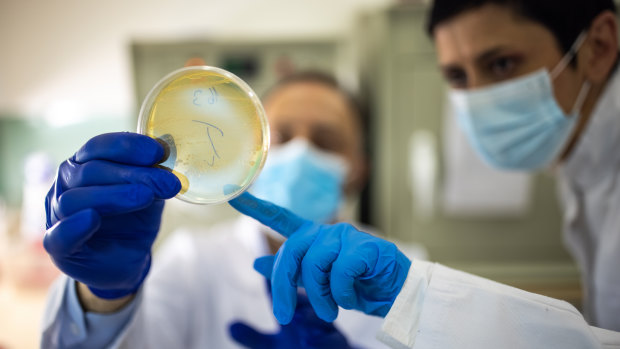
The WHO has warned of the world entering a post-antibiotic era, in which the drugs that we have come to rely on are far less effective.

Pfizer
Advertisement
- Sponsored
- Health & wellness
Strengthening Australia’s preparedness against emerging superbugs
Nikolaos Komilionis was 66, and on holiday in Greece, when he was admitted to hospital for minor surgery. It should have been a simple procedure, but after picking up a superbug that was resistant to antibiotics, he was soon fighting for his life.